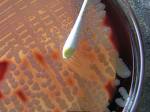

|
|
|
|
|
|
|
|
 |
|
|
|
||||
|
|
Can natural fungal pigments compete synthetic dyes in textile dyeing? Use of Natural plant material as colorants reflects the mood, status, landscape and very being of life. The increasing awareness of health and pollution hazards of chemical dyestuffs has led to a resurgence of interest in natural and mineral colors. Recently there has been increasing interest in using microorganism as a colour source since the cost efficiency; labor, extensive land requirement and use of expensive solvent for extraction in higher plant material. Therefore an investigation was undertaken microbial dyes The fungi such as Fusarium oxosporum, Trichodderma viride and Alternaria sp. were studied for colour production and tested on various cellulose fibers. An orange pigment from the fungi Ganoderma applanatum, Coriolus versicolor and Amanita muscaria was extracted from the basidiocarp and applied on the silk and cotton fabrics. The fungal pigment with different mordant like alum, copper, chromium, iron and tin developed colour variation from orange to yellow and deep green shades. Further the dyed cotton and silk fabrics did not change the colour in soap washing and sunlight drying. The cost efficiency, Labor, extensive land requirement and use of expensive solvent for extraction of pigments/ colour/dyes from higher plants are being heavily criticized. The fungal system can grow and produce colour within a short period of time in a limited space. For industries microbial dyeing technology will be highly advantageous compared to higher plants. The exploration of mushroom for colour / pigment production is very limited in India and extensive investigation on Mushroom dye Technology has a promising future for textile units in India. |
|
|||||||||||
|
|